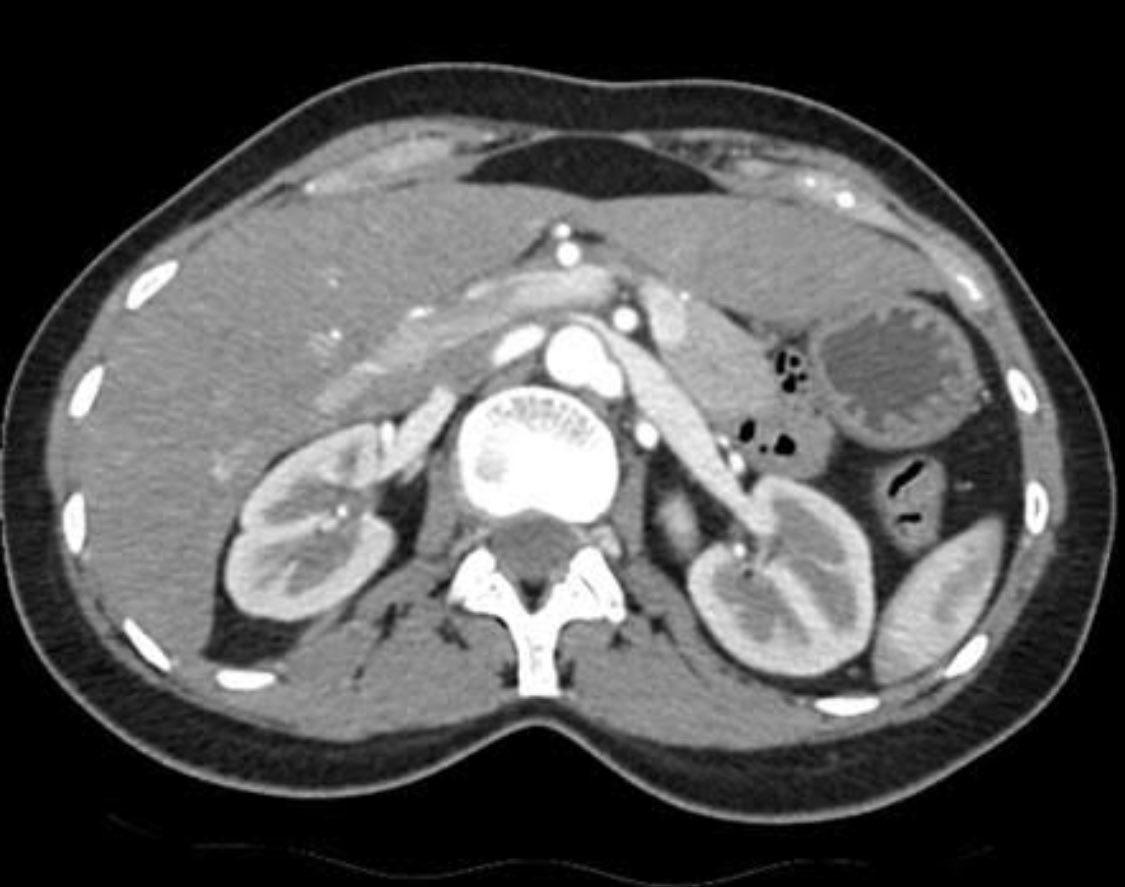
Olusegun Oyeniyi MD tweet media

Joyce Bwombengi retweetledi

The draft of the @goKDIGO 2026 Clinical Practice Guideline for Acute Kidney Injury (AKI) and Acute Kidney Disease (AKD) is now available for public review through 🗓️ April 27, 2026
#ISNWCN 🇯🇵 #WCN26 🇯🇵 #WCN2026 🇯🇵
#Nephpearls
You can download the guideline draft and submit comments via the feedback form
👉 kdigo.org/guidelines/acu…
👉 FEEDBACK Form surveymonkey.com/r/GTGNFHG




English